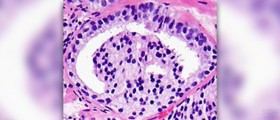
Function of prostate gland

Brain stem injury
Brain stem injury is a serious condition that can result in coma and death. It is a part of the body vital for proper body functioning. In this article, we...

Nose bleeds and high blood pressure
Nose bleeds may occur due to many factors. They also affect people of all ages. In adults with no previous anamnestic data in the sense of nose bleeds, frequent bleeding...

Inner ear infection treatment
Inner ear infection is also known as labyrinthitis. The labyrinth is a structure of the inner ear made of fluid-filled sacs and tubes. It comprises two organs, the cochlea, and...

Opiate withdrawal remedies
Opiate Withdrawal Remedies Opium poppy plant contains alkaloids called opioids which people refer to as “opiate”. Oxycontin, Vicodin, morphine, and even heroin can be a part of opiates. Lots of...

Intestinal parasites symptoms
Intestinal Parasites Symptoms Parasites that are found in the gastrointestinal tract are called intestinal parasites. Even though these parasites can live throughout the whole body, they are mostly found in...

Aging process in women
Aging and Women Women, as well as men, being of human origin, tend to get older and older as their life passes. During this period, numerous bodily changes are bound...

Degenerative bone disease
Degenerative bone disease is a term that can be applied to several conditions featured by degeneration of the bones. Types of Degenerative Bone Disease: Osteoporosis Osteoporosis is a disease in...

Blood in urine during pregnancy
Blood in urine is medically known as hematuria. Only if there are a lot of red blood cells in the urine, makes the urine look darker, which can be easily...

Carbon dioxide poisoning
Inhalation of high levels of carbon dioxide leads to a life-threatening condition known as hypercapnia or hypercarbia. Hypercapnia results in elevated levels of carbon dioxide in the blood, which is...

Toxic black mold exposure symptoms in humans
Black Toxic Mold - Overview Every one of us has some type of mold somewhere in the house. Not all types of mold are toxic for humans. Black toxic mold...

Potassium rich foods for diabetics
Potassium Rich Foods for Diabetics Lots of functions in the body, some of which are essential for well-being, are dependent on potassium. Potassium's main purpose is to make sure that...